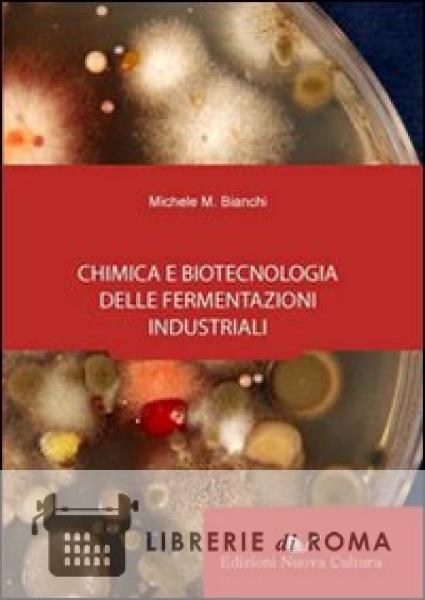

Attualmente non disponibile
A partire daIndicazioni sui tempi di disponibilità dei libri e significato delle classificazioni.
I tempi di disponibilità riportati su Librerie Di Roma sono stime basate esclusivamente sulla disponibilità e sull’elaborazione normale dell’ordine, in tempo reale e in automatico. Ogni libro indica nella Scheda Prodotto un tempo standard di disponibilità. Questo è il tempo minimo stimato come necessario per reperire il prodotto dai fornitori. In alcuni casi non prevedibili, il tempo effettivo di reperibilità potrebbe discostarsi da quello indicato nella Scheda Prodotto, in quanto dipende dal comportamento dei singoli fornitori, non dipendenti da Librerie Di Roma.
Laddove eccezionalmente sopraggiunga un caso di irreperibilità del prodotto, Librerie Di Roma lo comunicherà all’utente via e-mail, così come nell’ipotesi di indisponibilità del prodotto.
Significato delle classificazioni:

